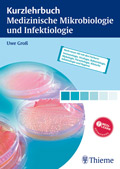

… nein, keine Ufos aus dem All, aber rechtzeitig zum Wintersemester 2007 wurde die eBook-Library des Thieme-Verlags um folgende 17 Online-Bücher ergänzt (Überblick in PDF) und enhält damit jetzt genau 99 Titel.
Anamnese und klinische Untersuchung, M. Neurath, A. Lohse
Anästhesie, J. Schulte am Esch, H. Bause, E. Kochs u.a.
Augenheilkunde, G. K. Lang
Biochemie, J. Rassow, K. Hauser, R. Netzker, R. Deutzmann Duale Reihe Biochemie
Klinische Pharmakologie, M. Wehling
Kurzlehrbuch Biologie, G. Poeggel
Kurzlehrbuch Chemie1., G Boeck
Kurzlehrbuch Embryologie, N. Ulfig
Kurzlehrbuch Medizinische Mikrobiologie und Infektiologie, U. Groß
Medizinethik – Für die neue AO, C. Wiesemann, N. Biller-Adorno
Neurologie, H.-W. Delank, W. Gehlen
Neurologie, K. F. Masuhr, M. Neumann
POL – Leitsymptome – Gastrointestinaltrakt, B. Block
POL – Leitsymptome – Herz-Kreislauf-System, B. Block
POL – Leitsymptome – Respiratorisches System, B. Block
Sonographie, S. Delorme, J. Debus
Taschenlehrbuch Orthopädie und Unfallchirurgie, N. Wülker
Sie können auf alle Bücher via http://www.thieme.de/ebooklibrary/ zugreifen, sofern Ihr Rechner im Hochschulnetz angemeldet ist (in der Bibliothek, im Institut, per Einwahl oder VPN).
